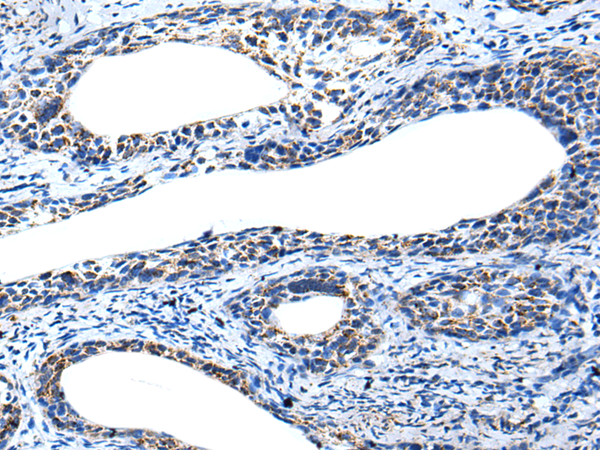

別 名: SLEB10
儲(chǔ) 存: 冷凍(-20℃)
技術(shù)規(guī)格
|
Background: |
This gene encodes a member of the interferon regulatory factor (IRF) family, a group of transcription factors with diverse roles, including virus-mediated activation of interferon, and modulation of cell growth, differentiation, apoptosis, and immune system activity. Members of the IRF family are characterized by a conserved N-terminal DNA-binding domain containing tryptophan (W) repeats. Multiple transcript variants encoding different isoforms have been found for this gene, and a 30-nt indel polymorphism (SNP rs60344245) can result in loss of a 10-aa segment. |
|
Applications: |
ELISA, WB, IHC |
|
Name of antibody: |
IRF5 |
|
Immunogen: |
Synthetic peptide of human IRF5 |
|
Full name: |
interferon regulatory factor 5 |
|
Synonyms: |
SLEB10 |
|
SwissProt: |
Q13568 |
|
ELISA Recommended dilution: |
5000-10000 |
|
IHC positive control: |
Human cervical cancer and human tonsil |
|
IHC Recommend dilution: |
25-100 |
|
WB Predicted band size: |
56 kDa |
|
WB Positive control: |
NIH/3T3,Hela,Jurkat,Hepg2 and A549 cell lysates |
|
WB Recommended dilution: |
500-2000 |

購(gòu)物車
幫助
021-54845833/15800441009
